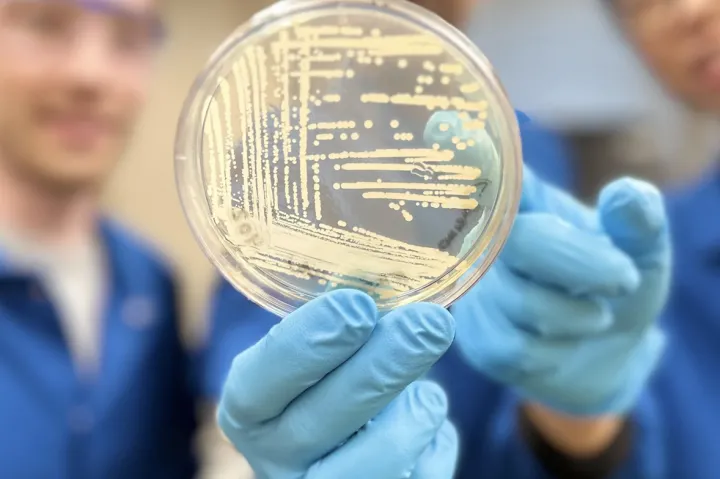
An agar plate containing colonies of Klebsiella pneumoniae bacteria, one of the drug-resistant strains the synthetic compound cresomycin has shown to combat.

Alert: Independence Day Office Closure
The Admissions & Financial Aid Office will be closed on Friday, July 4 for the Independence Day holiday. We will reopen with normal business hours on Monday, July 7.
Last Updated: July 03, 5:00pm
College News